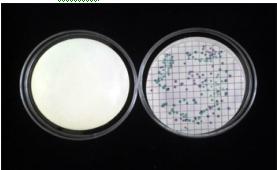
����

产品规格:
货号:LD-527 ,100片/盒
产品简介:
用于检测大肠杆菌O157的常规培养基是由山梨醇麦康凯琼脂构成,它对O157的特异性极差,常造成假阳性。山梨醇麦康凯琼脂培养基之所以如此难以读数是因为在延长的培养过程中会发生染色的改变。而大肠杆菌O157显色检测平板是一种显色的培养基,具有很高的特异性和敏感性。大肠杆菌O157显色检测平板在日本非常成功,它主要用在食品工业中检测大肠杆菌O157。
产品描述:
本品为针对大肠杆菌O157这一特定菌种的新型显色培养基,可以直接区分出大肠杆菌O157。
培养基包含特殊的发色底物,这种底物利用其特异的颜色使特定微生物在培养基上清晰可辨,非常便于识别。为了增强培养基对大肠杆菌O157的特异性,本品还为培养基补充了2,5mg/L的亚碲酸钾。
操作说明:
本品的使用方法和HY-LAB产品的基本使用法无甚差别。
1.直接将来自粪便的样品接种于大肠杆菌O157显色检测平板上,或利用如包被在特定微液滴上的0157抗体进行免疫捕捉,并在复苏法操作后进行次培养。
2.在37oC孵育过夜(24 小时)。
3.进行可靠而快速的观察和区分。
4.由血清测试来进行确认。
结果对照:
大肠杆菌O157 紫色菌落
大多数其他菌种 被抑制或为蓝色菌落
标准菌株质控图:
北京祥龙环宇生物技术有限公司
北京市朝阳区朝阳路财满街财经中心9号楼1单元702室 邮编100025
电话 010-65567512 传真010-65563420

 手机版
手机版






